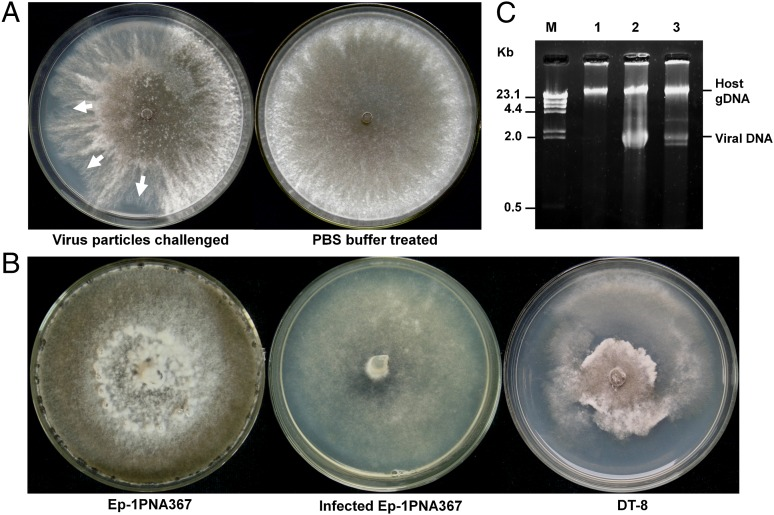
Plate assays mycovirus

Possible Mycovirus Control of White Mold
Researchers have discovered a mycovirus, SsHADV-1, which can infect Sclerotinia sclerotiorum.
Researchers have discovered a mycovirus, SsHADV-1, which can infect Sclerotinia sclerotiorum (Fig 1).This white mold pathogen infects hundreds of plant species including economically relevant species such as soybean. This research has recently come into greater focus with similar strategies being used to to control diseases such as chestnut blight. The research has begun to see success because of the discovery that viral particles can cause infection as free particles. SsHADV-1 was chosen because of it’s aggressive infection rate of fungal hosts. Researchers performed assays to probe it’s effectiveness by directly inoculating the plant with the virus followed by inoculation with the white mold. The mold then became infected when it entered areas which had been swabbed with the virus. The group also performed infection tests on plates which showed that the virus could contain the growth on the plate (fig 2). They also found that only intact viral particles could be used to infect the fungi, viral DNA wasn’t effective.
Further work in this area will need to include research on how the virus actually infects fungi and how the virus is naturally spread (insect vectors etc.). One other question is whether the virus could harm beneficial fungi. It seems likely that this virus could infect other, potentially beneficial fungi because SsHADV-1 – like sequences have been found integrated into fungal genomes such as Tuber melanosporum and Laccaria bicolor.
References:
- Mole, Beth. “Sick Mold A virus that infects a crop-killing fungus, opening the possibility of its use as a fungicide.” The Scientist.
- Yu, Xiao et al. “Extracellular transmission of a DNA mycovirus and its use as a natural fungicide” Proceedings of the National Academy of Sciences of the United States of America vol. 110,4 (2013): 1452-7.